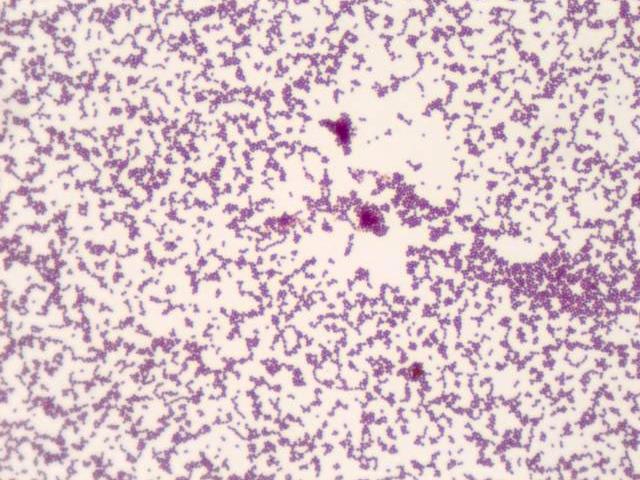

FREE DOMESTIC SHIPPING ON ORDERS OVER $100 📦
We Offer A Full Line Of Professional Microscopes 🔬
WE BUILD CUSTOM SOLUTIONS ⚙️
Have Questions? Give Us A Call! 718-961-8833, 9 am-5 pm ET.